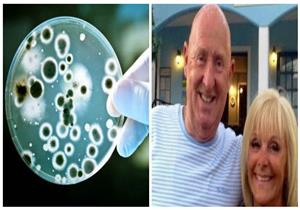
"مفيدة للإنسان"| كل ما تريد معرفته عن بكتيريا "إي كولاي".. قتلت سائحين

إعلان
-
22 نوفمبر, 2018
-
15 سبتمبر, 2018
-
12 سبتمبر, 2018
إعلان
الجزائر
بوركينا فاسو
غينيا الاستوائية
السودان
كوت ديفوار
الكاميرون
-

"عيب ولا يليق".. إعلامي يهاجم اتحاد الكرة بسبب كأس مصر خلال أمم إفريقيا
-

تحكيم مصري في مباراة مالي وجزر القمر بكأس الأمم الأفريقية
-

مدرب تونس السابق يكشف لمصراوي المنتخبات الأقرب للتتويج بأمم أفريقيا
-

تريزيجيه: قاتلنا بـ 10 لاعبين أمام جنوب أفريقيا.. وحسام حسن قدوة لنا جميعا
-

مدرب أنجولا يتحدي مصر: "هدفنا التأهل وهذا موقف شيكو بانزا"
أخبار منتخبات كأس الأمم الأفريقية

إعلان